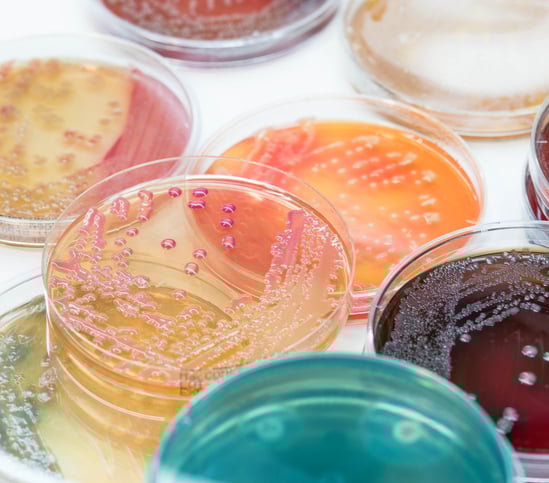

Una revisione sistematica pubblicata BMC Neurology ha analizzato i risultati dei cinque trial clinici che negli ultimi anni hanno valutato il trapianto di microbiota fecale (FMT) nella malattia di Parkinson. I dati sono incoraggianti per i sintomi intestinali, ma molto meno solidi sul fronte motorio. Il quadro complessivo è chiaro: il FMT è una tecnica promettente, sicura, ma ancora lontana dall’essere una terapia consolidata. E per capire se e per chi possa realmente funzionare serviranno studi più ampi, standardizzati e ben stratificati.
COME FUNZIONA IL TRAPIANTO DI MICROBIOTA FECALE
Di solito immaginiamo il Parkinson come una malattia che colpisce esclusivamente il cervello, manifestandosi con tremori, lentezza e rigidità. In realtà sappiamo da anni che in molti pazienti i sintomi partono dall’intestino, un organo densamente innervato e strettamente collegato al sistema nervoso centrale. Il microbiota intestinale, l’immenso ecosistema di microrganismi che vive in simbiosi con noi, sembra influenzare non solo la salute digestiva, ma anche l’immunità, l’infiammazione e, forse, il destino dei neuroni dopaminergici, le cellule che vanno incontro a degenerazione nel Parkinson.
Tra il 2020 e il 2024 diversi studi clinici hanno provato a capire se il trapianto di microbiota fecale (FMT) possa portare benefici ai pazienti. Quella pubblicata su BMC Neurology ha raccolto i risultati — non sempre concordi — di cinque trial clinici per un totale di 157 pazienti, evidenziando che questa tecnica è promettente ma ancora lontana dall’essere una terapia consolidata e che servono studi più ampi e meglio standardizzati per valutarne l’efficacia.
Il trapianto di microbiota fecale consiste nel trasferimento del microbiota di un donatore sano a un ricevente con una flora intestinale alterata. Il donatore deve essere sottoposto a una serie molto rigorosa di controlli infettivologici, metabolici, genetici e dietetici. «La procedura è complessa: il donatore deve essere sottoposto a diversi screening, che escludano la presenza di malattie croniche e la familiarità a patologie neoplastiche o infiammatorie dell’apparato digerente», spiega Flavio Caprioli, direttore della Gastroenterologia del Policlinico di Milano. «Purtroppo, poiché anche un paziente completamente sano può presentare contaminanti, solo circa il 5% dei candidati risulta idoneo».
Per aumentare questa percentuale, il Policlinico propone la donazione di microbiota ai donatori di sangue, già ampiamente selezionati: così l’idoneità sale al 20%. Il campione viene filtrato, diluito, testato e congelato; può essere conservato fino a un anno. La somministrazione (dopo una terapia antibiotica che riduce drasticamente il microbiota del ricevente) avviene tramite colonscopia, clistere o sondino naso-digiunale.
Oggi in Italia il trapianto fecale è approvato per una sola indicazione: l’infezione recidivante o refrattaria da Clostridium difficile, dove garantisce la guarigione in circa il 90% dei casi. Al di fuori di questa indicazione, è in fase di studio in numerose condizioni, tra cui malattie infiammatorie intestinali, alcuni tumori, disturbi depressivi resistenti e malattie neurodegenerative come il Parkinson.
QUANDO IL PARKINSON COMINCIA NELL’INTESTINO
«La malattia di Parkinson ha una lunga fase prodromica: la neurodegenerazione è spesso in atto da sei o sette anni quando il paziente arriva dal neurologo con i primi sintomi motori», spiega Giovanni Cossu, Responsabile del “Centro per la Diagnosi e Cura della Malattia di Parkinson e Disturbi del Movimento” dell’ARNAS Brotzu e Membro del Comitato Tecnico-Scientifico della Fondazione LIMPE.
Oggi si ritiene che esistano due sottotipi di malattia: il “brain-first”, quando il danno nasce nel cervello, e il “gut-first”, quando la malattia prende avvio nell’intestino.
«In questi ultimi pazienti — continua Cossu — la malattia può iniziare nell'intestino anni prima. I segnali d'allarme sono stitichezza cronica e irregolarità dell'alvo».
I pazienti presentano una disbiosi, uno squilibrio nelle percentuali di microorganismi che popolano l’intestino.
La carenza di batteri che producono acidi grassi protettivi come il butirrato rende la mucosa più permeabile e favorisce un’infiammazione cronica a livello intestinale.
Nelle cellule del sistema nervoso enterico, un ambiente infiammato e permeabile può favorire l’accumulo di alfa-sinucleina in forma alterata: è la stessa proteina che, aggregandosi, forma i corpi di Lewy tipici del Parkinson. Secondo la teoria “gut-first”, questi aggregati potrebbero risalire lungo il nervo vago fino al cervello, contribuendo così alla progressione della malattia. Si tratta di un modello plausibile e supportato da diverse evidenze sperimentali ed epidemiologiche, come il minore rischio di Parkinson osservato nei pazienti sottoposti in passato alla resezione del nervo vago, ma non ancora definitivo.
COSA DICONO GLI STUDI CLINICI
La revisione sistematica del 2025 conferma che il trapianto fecale è una procedura sicura, con effetti collaterali lievi e transitori, soprattutto gastrointestinali.
Sui sintomi intestinali i risultati sono incoraggianti: il FMT sembra migliorare la stitichezza e riequilibrare la motilità, un beneficio importante perché i disturbi dell’alvo pesano molto sulla qualità di vita dei pazienti.
Sul fronte dei sintomi motori, i dati sono più complessi. Uno studio belga pubblicato nel 2024 su EClinicalMedicine e condotto su 46 pazienti in fase iniziale della malattia ha evidenziato un miglioramento lieve ma significativo e duraturo dei sintomi motori. Al contrario, un trial finlandese pubblicato su JAMA Neurology e condotto su 45 pazienti in fase lieve-moderata non ha mostrato differenze rispetto al placebo e in alcuni casi ha rilevato un peggioramento transitorio.
Le divergenze potrebbero dipendere da diversi fattori: popolazioni di pazienti molto piccole, differenze nella via di somministrazione, stadi diversi della malattia e soprattutto l’uso di microbiota proveniente da donatori differenti. È possibile che alcune caratteristiche microbiche ancora da identificare siano particolarmente benefiche per una specifica categoria di pazienti, mentre in altri non mostrino effetti. Per capire queste dinamiche servono studi più grandi, controllati e ben stratificati.
Come sottolinea Cossu, «è improbabile che l'alterazione intestinale sia la causa principale della neurodegenerazione. Intervenire sul microbiota può correggere qualcosa che non funziona, ma non è detto che porti a risultati clinicamente significativi».
QUALE FUTURO DEL TRAPIANTO DI MICROBIOTA NEL PARKINSON?
Molte domande restano aperte, ma la ricerca avanza. Al momento in Italia non ci sono sperimentazioni attive dedicate al Parkinson, ma il Policlinico di Milano ha espresso l’intenzione di avviarne una nei prossimi anni. Rimangono da definire numerosi aspetti: il profilo del donatore ideale, il metodo di somministrazione più efficace, la necessità (o meno) di una preparazione antibiotica aggressiva e i pazienti che potrebbero beneficiarne di più.
Il futuro potrebbe essere quello di una medicina di precisione, capace di identificare il donatore perfetto per il paziente perfetto. L’idea che intervenire sull’intestino possa proteggere, almeno in parte, anche il cervello rimane affascinante. Ma perché questa possibilità diventi realtà serviranno studi più grandi, rigorosi e disegnati per rispondere alle molte domande ancora aperte.